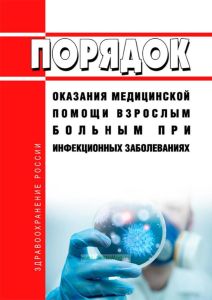
Порядок оказания медицинской помощи взрослым больным при инфекционных заболеваниях 2025 год. Последняя редакция

- Артикул:00-01017748
- ISBN: 978-5-953080-81-1
- Обложка: Мягкая обложка
- Издательство: ЦЕНТРМАГ (все книги издательства)
- Город: Москва
- Страниц: 28
- Формат: А5 (148x210 мм)
- Год: 2026
- Вес: 49 г
- Серия: Приказы Минздрава (все товары серии)
Документ продается с актуализацией на дату продажи!
Приказ Минздравсоцразвития России от 31.01.2012 N 69н "Об утверждении порядка оказания медицинской помощи взрослым больным при инфекционных заболеваниях".
Порядок оказания медицинской помощи взрослым больным при инфекционных заболеваниях утрвержден прикаом Минздравсоцразвития России от 31.01.2012 N 69н.
Порядок регулирует вопросы оказания медицинской помощи взрослым больным при инфекционных заболеваниях в медицинских организациях, за исключением вопросов оказания медицинской помощи взрослым больным при заболевании, вызванном вирусом иммунодефицита человека.
Содержание
Приложение. Порядок оказания медицинской помощи взрослым больным при инфекционных заболеваниях
Приложение N 1. Положение об организации деятельности отделения (кабинета) инфекционных заболеваний медицинской организации, оказывающей первичную медико-санитарную помощь
Приложение N 2. Рекомендуемые штатные нормативы медицинского и другого персонала отделения (кабинета) инфекционных заболеваний медицинской организации, оказывающей первичную медико-санитарную помощь
Приложение N 3. Стандарт оснащения отделения (кабинета) инфекционных заболеваний медицинской организации, оказывающей первичную медико-санитарную помощь
Приложение N 4. Положение об организации деятельности инфекционного отделения многопрофильной больницы (инфекционной больницы)
Приложение N 5. Рекомендуемые штатные нормативы медицинского и другого персонала инфекционного отделения многопрофильной больницы (инфекционной больницы)
Приложение N 6. Стандарт оснащения инфекционного отделения многопрофильной медицинской организации (инфекционной больницы) (с палатой интенсивной терапии на 3 койки)
Приложение N 7. Положение об организации деятельности инфекционной больницы
Приложение N 8. Рекомендуемые штатные нормативы медицинского и другого персонала инфекционной больницы